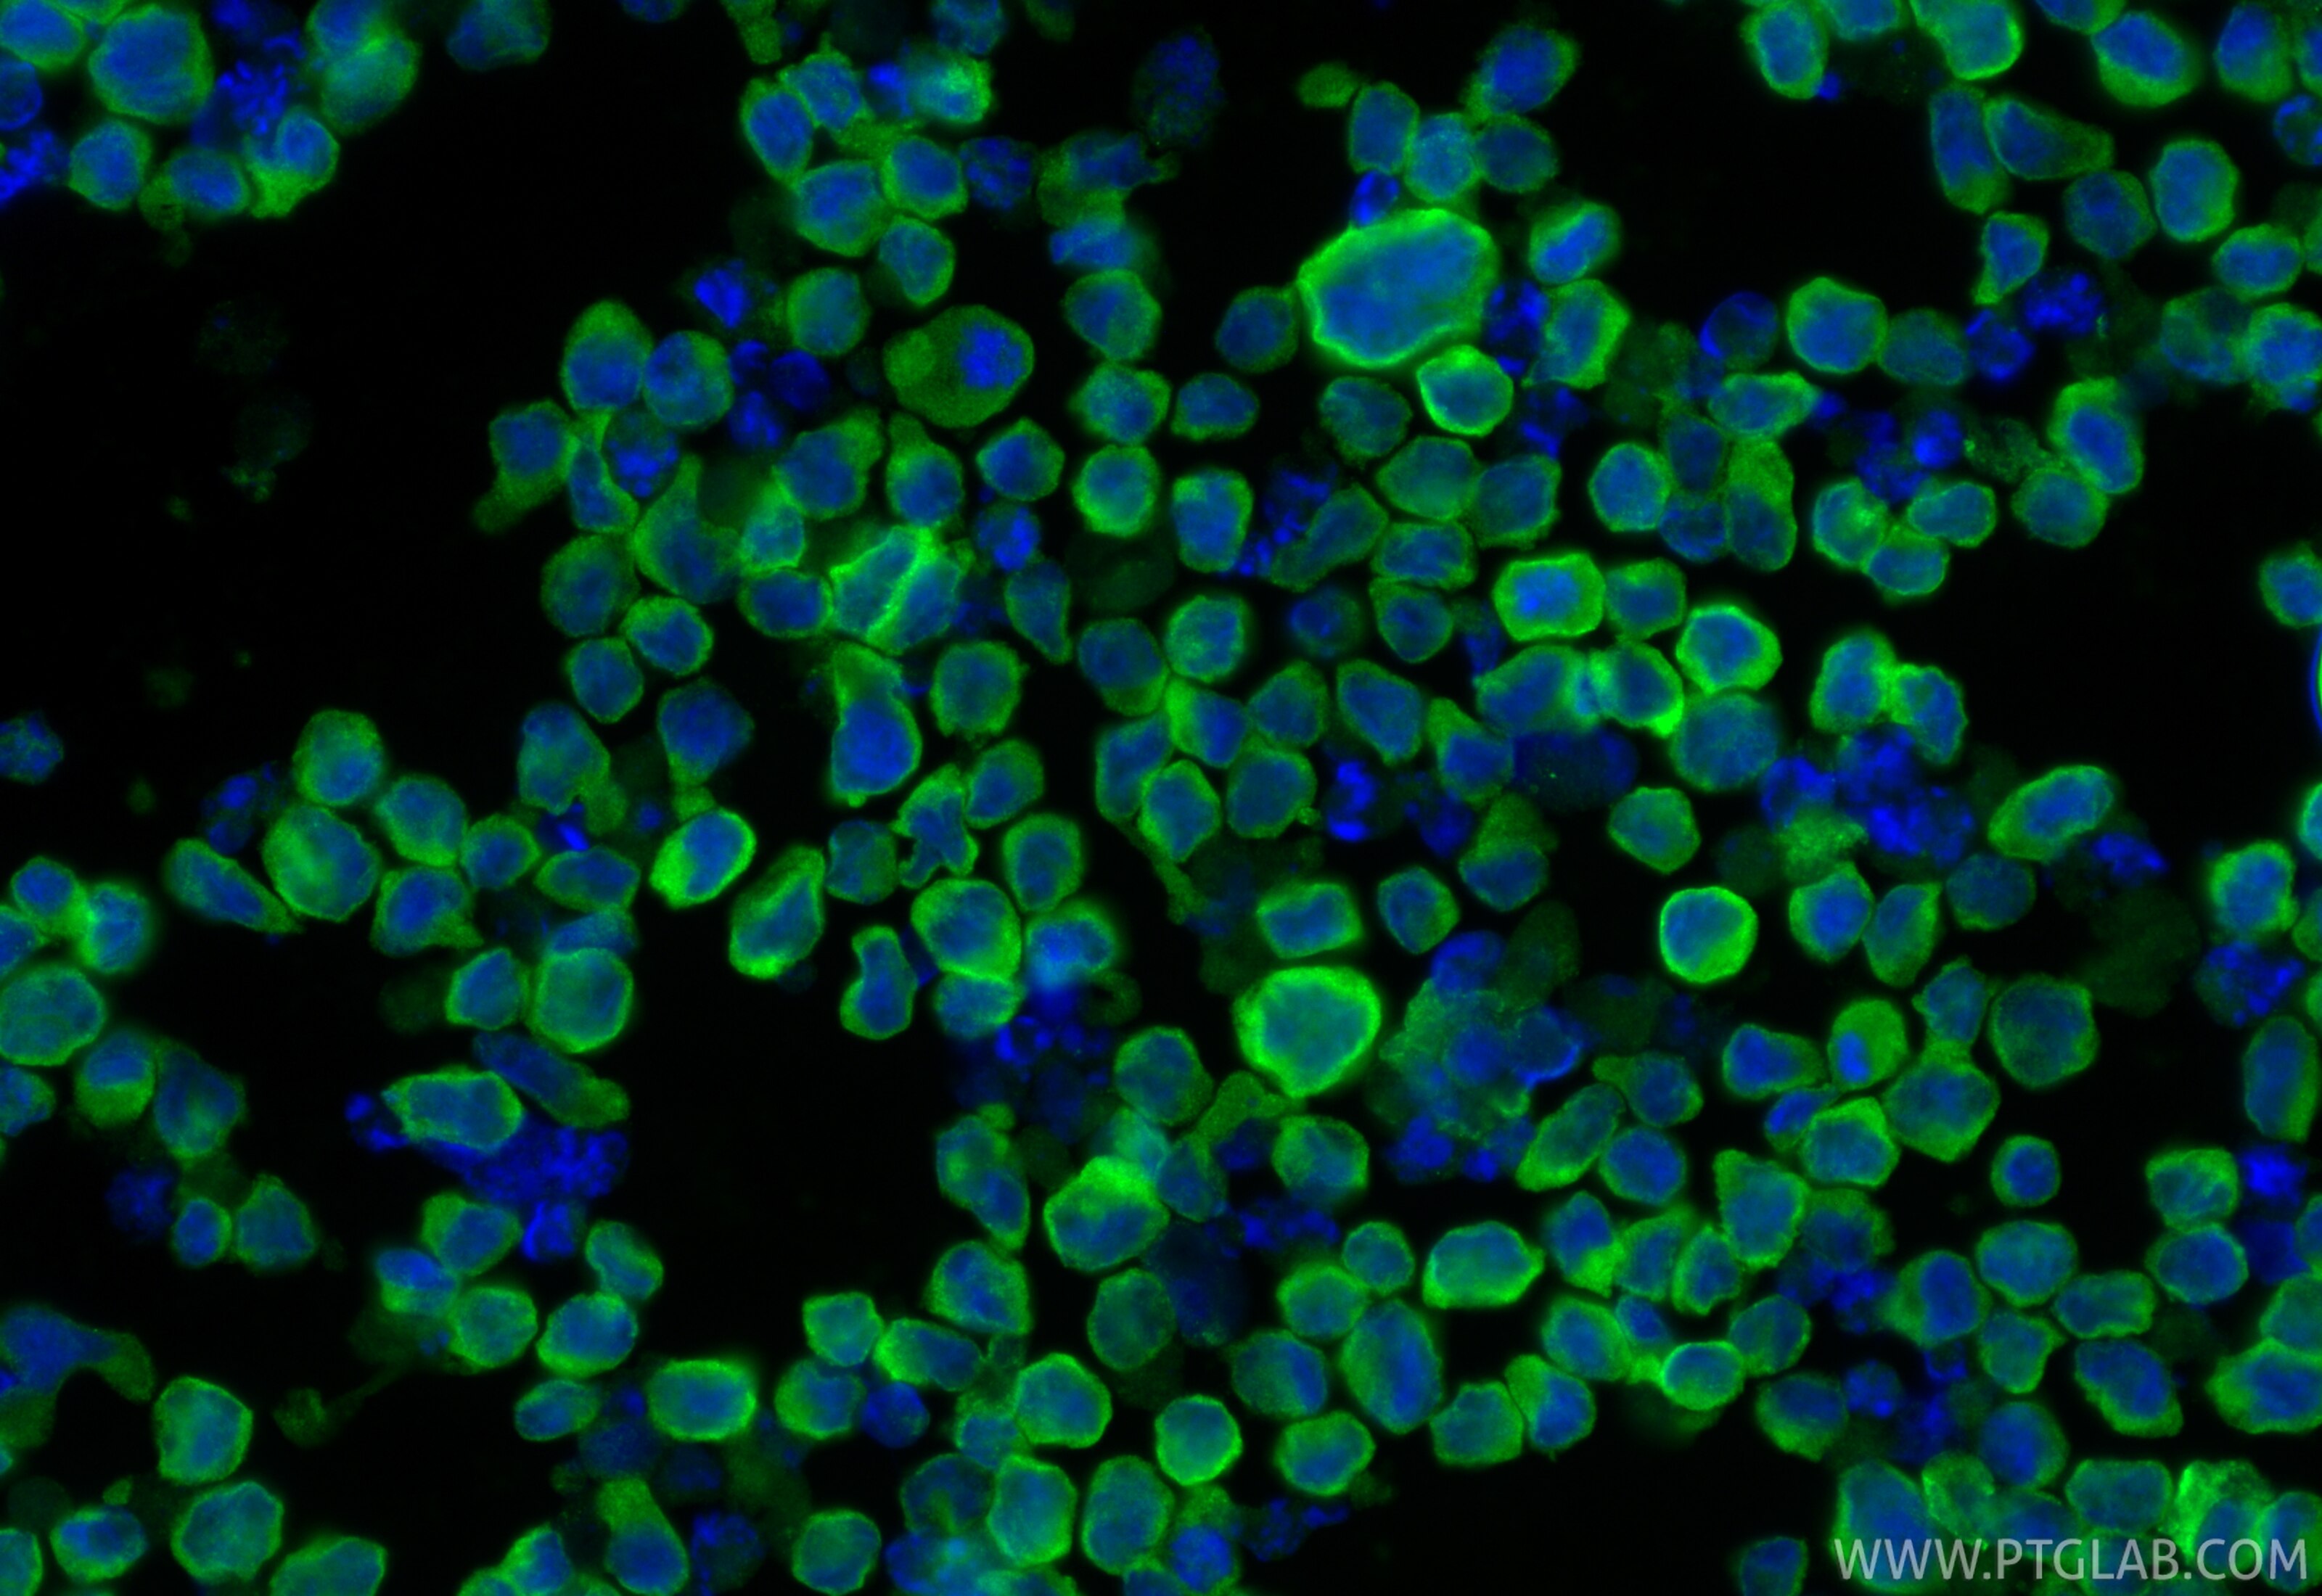
Immunofluorescence (IF) / fluorescent staining of NK-92 cells using KIR2DL4/CD158d Polyclonal antibody (32059-1-AP)

Validation Data Gallery
Tested Applications
| Positive WB detected in | HL-60 cells, NK-92 cells |
| Positive IF/ICC detected in | NK-92 cells |
Recommended dilution
| Application | Dilution |
|---|---|
| Western Blot (WB) | WB : 1:500-1:2000 |
| Immunofluorescence (IF)/ICC | IF/ICC : 1:200-1:800 |
| It is recommended that this reagent should be titrated in each testing system to obtain optimal results. | |
| Sample-dependent, Check data in validation data gallery. | |
Product Information
32059-1-AP targets KIR2DL4/CD158d in WB, IF/ICC, ELISA applications and shows reactivity with human samples.
| Tested Reactivity | human |
| Host / Isotype | Rabbit / IgG |
| Class | Polyclonal |
| Type | Antibody |
| Immunogen |
CatNo: Eg1895 Product name: Recombinant Human KIR2DL4 protein (rFc Tag) Source: mammalian cells-derived, pHZ-KIsec-C-rFc Tag: C-rFc Domain: 24-242 aa of BC041611 Sequence: HVGGQDKPFCSAWPSAVVPQGGHVTLRCHYRRGFNIFTLYKKDGVPVPELYNRIFWNSFLISPVTPAHAGTYRCRGFHPHSPTEWSAPSNPLVIMVTGLYEKPSLTARPGPTVRAGENVTLSCSSQSSFDIYHLSREGEAHELRLPAVPSINGTFQADFPLGPATHGETYRCFGSFHGSPYEWSDPSDPLPVSVTGNPSSSWPSPTEPSFKTGIARHLH 相同性解析による交差性が予測される生物種 |
| Full Name | killer cell immunoglobulin-like receptor, two domains, long cytoplasmic tail, 4 |
| Calculated molecular weight | 377 aa, 42 kDa |
| Observed molecular weight | 45 kDa |
| GenBank accession number | BC041611 |
| Gene Symbol | KIR2DL4 |
| Gene ID (NCBI) | 3805 |
| RRID | AB_3670180 |
| Conjugate | Unconjugated |
| Form | |
| Form | Liquid |
| Purification Method | Antigen affinity Purification |
| UNIPROT ID | Q99706 |
| Storage Buffer | PBS with 0.02% sodium azide and 50% glycerol{{ptg:BufferTemp}}7.3 |
| Storage Conditions | Store at -20°C. Stable for one year after shipment. Aliquoting is unnecessary for -20oC storage. |
Background Information
Killer cell immunoglobulin-like receptors (KIRs) are transmembrane glycoproteins expressed by natural killer cells and subsets of T cells that regulate their responsiveness to signals received from their environment (PMID: 22934097). Killer cell immunoglobulin-like receptor 2DL4 (KIR2DL4, also known as CD158D and KIR103AS) is an unusual member of the KIRs family, which activates the cytotoxicity of NK cells. KIR2DL4 has two immunoglobulin domains and a single immunoreceptor tyrosine-based inhibition motif (ITIM) in the cytoplasmic tail with weak inhibitory potential (PMID: 12055234).
Protocols
| Product Specific Protocols | |
|---|---|
| IF protocol for KIR2DL4/CD158d antibody 32059-1-AP | Download protocol |
| WB protocol for KIR2DL4/CD158d antibody 32059-1-AP | Download protocol |
| Standard Protocols | |
|---|---|
| Click here to view our Standard Protocols |